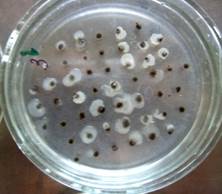
Изображение выглядит как дуршлаг, внутренний, кухонная посуда, чашка

Автоматически созданное описание

МУНИЦИПАЛЬНОЕ БЮДЖЕТНОЕ ОБЩЕОБРАЗОВАТЕЛЬНОЕ УЧРЕЖДЕНИЕ
«СРЕДНЯЯ ОБЩЕОБРАЗОВАТЕЛЬНАЯ ШКОЛА №12 СТАНИЦЫ НЕЗЛОБНОЙ»
|
|
|
|
Дополнительная общеобразовательная общеразвивающая программа
естественнонаучной направленности
«Юный почвовед. Охотник за микробами»
(ТОЧКА РОСТА)
Возраст обучающихся: 12-15 лет
Срок реализации: 1 год
Учитель высшей квалификационной категории: Саламатина Надежда Анатольевна
станица Незлобная
2024
ОГЛАВЛЕНИЕ
1. Пояснительная записка…………………………………………………………..…….3
2. Учебный план программы…………………………………………………………….7
3. Ресурсное обеспечение программы…………………………………………………..8
4.Методическое обеспечение……………………………………………………………22
5. Литература……………………………………………………………………………..23
1.Пояснительная записка
Актуальность. Почвоведение – это наука о почве, которая изучает ее свойства, состав, структуру и функции. Изучение почвоведения имеет большое значение для понимания процессов, происходящих в окружающей среде, и для решения экологических проблем.
Почва является главным элементом биосферы, она участвует в круговороте веществ и энергии в природе, обеспечивает жизнь растений и животных. Однако почва подвергается негативному воздействию со стороны человека, что может привести к ее деградации и потере плодородия.
Изучение почвоведения помогает обучающимся понимать, как правильно использовать ресурсы земли, сохранять биоразнообразие и предотвращать экологические катастрофы. Обучающиеся могут узнать о методах изучения почвы, ее свойствах и составе, почвенных микроорганизмах, а также о том, как их можно использовать в сельском хозяйстве и других отраслях.
Кроме того, изучение почвоведения способствует развитию экологического мышления и ответственного отношения к окружающей среде. Обучающиеся учатся ценить природу и заботиться о ее сохранении для будущих поколений.
Таким образом, изучение почвоведения является актуальным и важным, так как оно помогает им понять процессы, происходящие в природе и научиться принимать экологически обоснованные решения. Экологическое воспитание учащихся сегодня является одной из важнейших задач общества, а значит, и образования. Занятия в кружке позволяют восполнить этот недостаток хотя бы для учащихся, интересующихся биологией
Авторская дополнительная общеобразовательная общеразвивающая программа «Юный почвовед. Охотник за микробами.» разработана в соответствии с нормативно-правовыми документами:
1. Стратегия развития воспитания в Российской Федерации на период до 2025 года (утверждена распоряжением Правительство РФ от 29.05.2015 №996-р).
2. Порядок организации и осуществления образовательной деятельности по дополнительным общеобразовательным программам (утвержден приказом Министерства образования и науки РФ от 29.08.2013 № 1008).
3. Санитарно-эпидемиологические требования к устройству, содержанию и организации режима работы образовательных организаций дополнительного образования детей (утверждено постановлением Главного государственного санитарного врача РФ от 04.07. 2014 № 41).
4. Общие требования к определению нормативных затрат на оказание государственных (муниципальных) услуг в сфере образования, науки и молодежной политики, применяемых при расчете объема субсидии на финансовое обеспечение выполнения государственного (муниципального) задания на оказание государственных (муниципальных) услуг (выполнения работ) государственным (муниципальным) учреждением (утверждены приказом Министерства образования и науки РФ от 22.09.2015 № 1040).
5. Методические рекомендации по проектированию дополнительных общеразвивающих программ (включая разноуровневые программы) (Приложение к письму Департамента государственнойполитикевсферевоспитаниядетейимолодежиМинистерстваобразованияи науки РФ от 18.11.2015 № 09- 3242).
6. О внеурочной деятельности и реализации дополнительных общеобразовательных программ (Приложение к письму Департамента государственной политики в сфере воспитания детей и молодежи Министерства образования и науки РФ от 14.12.2015 № 09-3564).
7. Примерные требования к программам дополнительного образования детей (Приложение к письму Департамента молодежной политики, воспитания и социальной поддержки детей Министерство образования и науки РФ от 11.12.2006 № 06-1844).
8. Уставом Муниципального бюджетного общеобразовательного учреждения «Средняя общеобразовательная школа №12 станицы Незлобной»
Направленность программы: естественнонаучная.
Новизна данной программы состоит в том, что она является уникальной для Георгиевского района. В ходе реализации программы используются современные технологии и методы исследования почвы, для проведения которых используется оборудование центра «Точки роста».Программа направлена на внедрение исследовательского метода в практику дополнительного образования и включает в себя региональный компонент, то есть посвящена экологическим проблемам своего населённого пункта, где живет школьник, то есть всему, что его окружает. Новизна данного курса заключается в личностно – ориентированном подходе к образовательному процессу и развитии творческой инициативы учащихся.
Отличительной особенностью программы является заключенный договор о сотрудничестве с ФГАОУ ВО «Новосибирский национальный исследовательский государственный университет» при поддержке Фонда «Образование». Организация исследований в области почвенных микроорганизмов» с использованием дистанционных образовательных технологий. ФГАОУ ВО предоставил оборудование и методики для изучения почв, позволил использовать при организации образовательного процесса разнообразные научные материалы об особенностях почв, а также использовать приборную базу микро лабораторий. Основными задачами сотрудничества является участие обучающихся МБОУ «СОШ № 12» станицы Незлобной в Исследовательской программе «Всероссийский атлас почвенных микроорганизмов, как основа для поиска новых противомикробных продуцентов и ферментов с уникальными свойствами», реализуемой в рамках Федеральной научно-технической программы развития генетических технологий на 2019 – 2027 годы при поддержке Министерства науки и высшего образования Российской Федерации. Участие в Программе предполагает формирование умений практического характера, что позволяет учащимся внести реальный вклад в сбережение природной среды своей местности.
Педагогическая целесообразность.
Изучение почвы, ее свойств и азотофиксирующих бактерий живущих в ней может заинтересовать обучающихся и помочь им развить интерес к науке. Изучение почвоведения может помочь лучше понимать мир вокруг себя и его связь с окружающей средой. Обучающиеся могут узнать о различных типах почв, их свойствах и использовании в сельском хозяйстве, лесоводстве и других отраслях. Это поможет им развить критическое мышление и расширить свой кругозор.
Изучение почвоведения может способствовать экологическому просвещению и воспитанию ответственного отношения к природе. Обучающиеся могут понять, как неправильное использование почвы может привести к негативным последствиям для окружающей среды.
Если обучающиеся планируют связать свою карьеру с сельским хозяйством, лесной промышленностью или другими профессиями, связанными с использованием и управлением почвами, изучение почвоведения поможет им получить необходимые знания и навыки.
Изучение почвоведческих методов и проведение экспериментов могут помочь развивать исследовательские и аналитические навыки, которые могут быть полезными в будущем.
В целом, программа «Юный почвовед» может быть полезной и интересной для учащихся, которые интересуются наукой и окружающей средой, а также для тех, кто планирует связать свою карьеру с профессиями, связанными с землей и природой.
Количество часов по программе в год – 34.
По продолжительности реализации программа – одногодичная.
Занятия проводятся с группой 1 раз в неделю по 1 часу.
Форма организации образовательного процесса – групповая.
По содержанию деятельности – интегрированная.
Уровень сложности – стартовый.
По уровню образования – общеразвивающая.
Цель и основные задачи программы.
Цель программы – формирование у обучающихся знаний о почвах и почвенных микроорганизмах, их свойствах, структуре и функциях, а также развитие интереса к изучению этой науки и ее роли в жизни человека. Программа направлена на развитие у обучающихся навыков работы с почвенными образцами, проведение лабораторных исследований и анализ полученных результатов.
Задачи:
Воспитательные задачи:
1. Формирование у детей ответственного и бережного отношения к окружающей среде.
2. Развитие навыков работы в коллективе и коммуникативных навыков.
3. Формирование навыков самостоятельного обучения и работы с научной литературой.
4. Стимулирование и мотивация обучающихся к личностному развитию, расширению кругозора в многообразии профессий.
5. Формирование у обучающихся универсальных компетенций, способствующих эффективности в профессиональной деятельности.
Развивающие задачи:
1. Развитие устойчивого познавательного интереса кизучению почвоведения.
2. Развитие интереса к научным исследованиям и экспериментам.
3. Формирование навыков работы с лабораторным оборудованием и приборами.
4. Развитие умения анализировать результаты экспериментов и делать выводы.
5. Развитие умения определять цели и задачи согласно тематике работы при проведении исследования и строго действовать в достижении их.
6. Обучение работе с научной литературой и источниками информации.
7. Развитие логического и критического мышления и умения решать проблемы.
Образовательные задачи:
1. Изучение основных понятий и терминов почвоведения, таких как почва, ее состав, структура, свойства и функции. Азотофиксирующие бактерии.
2. Исследование свойств почв, включая физические, химические и биологические характеристики.
3. Изучение методов анализа почвы, таких как химический анализ, микроскопия, и другие.
4. Ознакомление с методами мониторинга состояния почвы и ее изменения под влиянием различных факторов.
5. Разработка и проведение исследований по изучению влияния различных факторов на свойства почвы.
Планируемые результаты освоения программы:
Предметные результаты:
- Знают основные понятия и термины, связанные с почвой и почвенными процессами.
- Умеют проводить анализ почвы и оценивать ее свойства, такие как гранулометрический состав, содержание органических веществ, кислотность и др.
- Понимают роль почвы в экосистемах и ее влияние на здоровье человека и окружающую среду.
- Знают методы исследования почвы и умеют применять их на практике.
- Способны использовать полученные знания для решения практических задач, связанных с изучением и использованием почвы.
- Имеют навыки работы с лабораторным оборудованием и навыки проведения экспериментов по изучению свойств почвы.
Личностные результаты:
- Проявлять чувства гордости и ответственности за свою малую родину;
- Проявлять аккуратность, трудолюбие, общественную активность, умение сочетать общественные и личные интересы;
- Видеть результаты и перспективы своей работы;
- Воспринимать адекватно требования;
- Относиться к обучению положительно;
- Демонстрировать навыки культуры общения;
Метапредметные результаты:
Познавательные
1. Самостоятельно определять цели своего обучения, ставить и формулировать для себя новые задачи в познавательной деятельности.
2. Умеют корректировать свои действия в соответствии с изменяющейся ситуацией.
3. Умеют создавать, применять и преобразовывать знаки и символы, модели и схемы для решения учебных и познавательных задач.
4. Владеют навыками смыслового чтения.
Коммуникативные
1. Имеют навыки развития компетентности в области использования информационно-коммуникационных технологий.
2. Умеют организовывать учебное сотрудничество и совместную деятельность с учителем и со сверстниками, работать индивидуально и в группе.
3. Умеют осознанно использовать речевые средства для выражения своих чувств, мыслей и потребностей.
Регулятивные
1. Умеют строить логическое рассуждение, умозаключение и делать выводы.
2. Умеют определять понятия, создавать обобщения, устанавливать аналогии, классифицировать.
3. Умеют оценивать правильность выполнения учебной задачи, собственные возможности ее решения.
4. Владеют основами самоконтроля, самооценки, принятия решений и осуществления осознанного выбора в учебной и познавательной деятельности.
2. УЧЕБНЫЙ ПЛАН ПРОГРАММЫ
|
№ № п/п |
Название модуля |
Теория |
Практика |
Всего |
|
11 |
Общее почвоведение |
1 |
0 |
1 |
|
22 |
Азотофиксирующие бактерии. |
15 |
0 |
15 |
|
33 |
Экологический практикум. |
0 |
19 |
19 |
|
Всего часов |
15 |
19 |
34 |
|
Учебно-тематический план
|
№ п/п |
Название раздела и темы программы |
Теория |
Практика |
Всего |
|
1 |
Введение в программу. Почвоведение как наука. |
3 |
0 |
3 |
|
2 |
Какими бывают микробы? |
1 |
0 |
1 |
|
3 |
Деятельность микробов. |
2 |
0 |
2 |
|
4 |
Бактерии. |
1 |
0 |
1 |
|
5 |
Строение бактерий. |
2 |
1 |
3 |
|
6 |
Азотофиксирующие бактерии. |
1 |
0 |
1 |
|
7 |
Изучение почвенного дыхания. |
1 |
3 |
4 |
|
8 |
Содержание органических веществ в почве. |
1 |
3 |
4 |
|
9 |
Посев и наблюдение за ростом колоний азотофиксирующих бактерий. |
1 |
3 |
4 |
|
10 |
Микроскопическое исследование образцов азотобактера. |
1 |
3 |
4 |
|
11 |
Исследование способности бактерий к накоплению полимерных удобрений. Плодородие почвы. |
1 |
3 |
4 |
|
12 |
Итоговое занятие. |
0 |
3 |
3 |
|
|
Итого: |
15 |
19 |
34 |
3.РЕСУРСНОЕ ОБЕСПЕЧЕНИЕ ПРОГРАММЫ.
Понятие о почве. Роль почвы в природе и обществе. Почвоведение в системе наук. Становление почвоведения как науки. Морфология почв и гранулометрический состав. Строение почвенного профиля. Мощность почвы. Окраска почвы. Влажность почвы. Структура почв. Сложение почвы. Новообразования и включения. Гранулометрический и скелетный состав почв.
К микробам (микроорганизмам) относятся археи, грибы, протисты и, конечно же, бактерии. Большинство микробов состоят из одной клетки, а их размер составляет менее 0,1 мм. Микробы незаметны, но присутствуют во всех возможных средах: они ползают по дну океанических впадин, копошатся в снегах Антарктиды, заселяют почвы, парят высоко над нами вместе с облаками и, наконец, буквально кишат в нашем организме (количество клеток бактерий в человеческом теле в десятки раз превышает количество собственных клеток организма). Все микробы отличаются друг от друга по величине, форме, размерам, строению, подвижности, отношению к внешней среде (температуре, влажности и т. д.), характеру питания и дыхания. Для одних микробов (аэробов) необходим кислород, а для других (анаэробов) он не нужен.
В СМИ часто освещается патогенное влияние микробов на организм человека и окружающую среду. Действительно, некоторые микроорганизмы могут служить причиной инфекционных заболеваний или оказывать пагубное влияние на жизнедеятельность растений. С другой стороны, микробы являются важной частью экосистемы и выполняют в ней полезные функции.
Функции микробов в организме человека:
- преобразование углеводов в молочную кислоту, которая препятствует развитию вредных микробов (осуществляется лактобактериями);
- снабжение организма человека естественными антибиотиками;
- участие в процессах синтеза различных витаминов;
- положительное влияние на функцию опорожнения кишечника;
- стимулирующее действие на иммунную систему организма.
Функции микробов в почвенной среде:
- превращение перегноя в минеральные вещества, которые способны поглощать корни растений;
- поглощение азота из воздуха с последующим синтезом азотных соединений, и, таким образом, обогащение почвы.
Функции микробов в водной среде:
- окисление сероводорода до серной кислоты и предотвращение гибели рыбы;
- очищение воды от различных отходов.
Бактерии являются прокариотами – одноклеточными организмами, которые не обладают оформленным клеточным ядром. Бактерии могут вести жизнедеятельность в широком диапазоне температур (как положительных, так и отрицательных), в кислой и щелочной среде (при рН от 0 до 10), при давлении до 1000 атмосфер. Бактерии обитают в почве, на дне озер и океанов и даже в соленых морях и на холодных вершинах гор. В Мертвом моры были обнаружены бактериальные организмы, которые способны функционировать в условиях экстремально соленой среды. Количество бактерий атмосфере коррелирует с запыленностью воздуха. Так, городская дождевая вода содержит гораздо больше бактерий, аналогичные дождевые стоки в сельской местности.
Бактерии обладают микрометровыми размерами (1 микрометр = 10-6 метра): «толщина» одного организма находится в диапазоне 0,5–2,0 мкм, а длина – 1,0–8,0 мкм. Бактериальные клетки имеют чрезвычайно разнообразную морфологию (форму и размер). Наиболее распространенными являются кокки (бактерии со сферическим строением), бациллы (палочки или цилиндры с закругленными концами), спириллы (жесткие спирали) и спирохеты (тонкие и гибкие волосовидные формы) (Рисунок 1).
|
|
|
Рисунок 1. Морфологическое разнообразие бактерий |
Тема 5. СТРОЕНИЕ БАКТЕРИЙ. 2ч
В структуре клетки бактерии, как правило, отсутствуют крупные мембранные органеллы, такие как ядро, митохондрии, хлоропласты. У бактерий имеется многокомпонентный цитоскелет, который контролирует локализацию нуклеиновых кислот и белков внутри клетки и управляет клеточным делением. Генетический материал бактерии зашифрован хромосомной ДНК, которая представлена длинной кольцевой молекулой. Надо отметить, что помимо хромосомной ДНК бактерии зачастую содержат плазмиды – кольцевые двуцепочечные молекулы ДНК небольшого размера. Плазмиды отвечают за приспособленность бактерий к окружающей среде, например, содержат гены устойчивости к разным антибиотикам.
Бактериальная клетка окружена мембраной, химической основой для которой служат фосфолипиды. Мембрана окружает всё содержимое клетки и является барьером, который удерживает в клетке питательные вещества, белки и другие компоненты цитоплазмы. Мембрана большинства бактерий покрыта толстой клеточной стенкой, которая не дает бактериальной клетке лопнуть, когда в нее за счет осмоса поступает вода. У части бактерии за «слоем» клеточной стенки следует «слой» защитной слизистой капсулы (Рисунок 2). Как правило, такие бактерии характеризуются толстой клеточной стенкой. В организмах других бактерий поверх тонкой клеточной стенки располагается ещё один слой мембраны, после которого следует слизистая капсула. Бактерии, не имеющие «второго слоя» мембраны, носят название «грамположительных». Название «грамположительные» обусловлено приобретением бактериями фиолетового цвета при окрашивании по методу Грамма. Толстая клеточная стенка таких бактерий препятствует вымыванию красителя и, следовательно, является причиной их окрашивания (Рисунок 3).
Многие бактерии ведут подвижный образ жизни. Для осуществления двигательных функций бактериальные организмы снабжены жгутиками. Ещё одной внешней структурой бактерий являются пили — полые белковые структуры, расположенные на поверхности клетки. Пили бактерии используют в процессе конъюгации – однонаправленном переносе плазмидной ДНК или геномной ДНК.

Рисунок 2. Строение бактерии

Рисунок 3. Строение "грамположительных"(слева) и "грамотрицательных"(справа) бактерий
Тема 6. АЗОТФИКСИРУЮЩИЕ БАКТЕРИИ. 1ч
Азотфиксация — это процесс переведения молекулярного азота из атмосферы (N2) в восстановленную растворимую форму. Растворимые соединения азота доступны для усваивания растениями, а почва, насыщенная такими соединениями, считается более плодородной. Содержание и соотношение растворимых форм азота в почве постоянно изменяются в результате их усвоения растениями, сбором урожая, а также вследствие эрозии, вымывания и денитрификации. Описанные процессы относят соединения азота к одному из главных и дефицитных элементов питания естественных и сельскохозяйственных экосистем, а азотфиксаторы играют важную роль в круговороте азота в природе и биосфере в целом (Рисунок 4).

Рисунок 4. Круговорот азота в природе
Азотфиксацию способны осуществлять прокариоты, тогда как у эукариот отсутствуют гены, ответственные за данный процесс. Наиболее известные азотфиксирующие симбиотические бактерии – Rhizobiumsp. – используются в производстве биологических удобрений для бобовых растений. Между бобовыми культурами и азотфиксирующими бактериями возникает симбиоз, следствием которого является увеличение содержания на посевной площади высококачественного легкоусвояемого белка.
Azotobacter — это род свободноживущих грамотрицательных бактерий, обитающих в почве. Azotobacterchroococcum был впервые выделен в чистой культуре голландским ученым М. Бейеринком в 1901 г.
Представители рода Azotobacterчаще всего обитают в нейтральных и слабощелочных почвах, а также в пресноводных водоемах и солоноватоводных болотах. Однако, некоторые представители Azotobacter были обнаружены и в экстремальных условиях: в почвах северного и южного полярного и антарктического региона. Azotobacter нередко образуют симбиотическую связь с растениями и живут в ризосфере – узком слое почвы, прилегающем к корням растения толщиной около 2-5 мм. Представители данного рода получают энергию в ходе окислительно-восстановительных реакций, используя углеводы, спирты и соли органических кислот. Азотфиксаторы способны фиксировать по крайней мере 10 микрограмм (микрограмм = 10-6 грамм) азота на один грамм потреблённой глюкозы. Бактерии Azotobacter способны расти и осуществлять процесс фиксации азота в диапазоне pH от 4,8 до 8,5, а оптимальным для жизнедеятельности данных организмов считается диапазон pH 7,0—7,5.
Дефицит питательных элементов, засоление почв, наличие тяжелых металлов, биоциды, ограниченная влажность и сочетание всех вышеперечисленных неблагоприятных условий может приводить к исчезновению популяции азотфиксаторов и изменению микробиоценоза почвы. Задача поиска штаммов азотфиксаторов, устойчивых к дефицитным (стрессовым) условиям, является очень актуальной. Современные исследователи регулярно находят и описывают новые азотфиксирующие бактерии, однако их внедрение в сельское хозяйство затрудняется низкой азотфиксирующей активностью в стрессовых условиях.
В рамках данного проекта участникам предлагается стать «Охотниками за бактериями» и попробовать отыскать интересные с научной точки зрения виды азотфиксирующих бактерий.
«Дыхание почвы» - процесс образования СО2 в результате разложения и окисления органического вещества почвенными микроорганизмами и корнями растений. В данном разделе представлена инструкция по изучению почвенного дыхания: определению количества CO2, которое выделяет почва (в данной методике мы используем Абсорбционный метод по Шаркову 1984г.). Для выполнения исследования вам потребуются следующие компоненты набора «Охотник за микробами»:
- Перчатки;
- Емкости для тирования;
- Соляная кислота 0,1 M;
- NaOH 0,1 M;
- Фенолфталеин;
- Капельница 15 мл;
- Пипетки Пастера на 5 мл.
Подготовка проб:
Если в вашей лаборатории нет аналитических весов, то для подготовки навесок вы можете использовать бытовые (кухонные) весы.
1) Подготовьте 3 одинаковые емкости объемом 0,5 или 1 л с герметично закрывающейся крышкой;
Подойдут стеклянные банки или контейнеры для пищевых продуктов с винтовой крышкой.
2) Промаркируйте емкости номерами 1, 2 и 3 с помощью перманентного маркера;
3) Взвесьте емкости и зафиксируйте их массу в лабораторном журнале;
4) На весах подготовьте две одинаковые навески почвы: если вы используете влажную почву, то масса навески должна составить 150 г, если сухую – 100 г;
5) Перенесите навески почвы в емкости №2 и 3;
Если массы навесок отличаются, зафиксируйте в журнале массу навески и номер контейнера, в который была помещена эта навеска.
6) Распределите почву ровным слоем по дну емкостей;
7) Подготовьте и пронумеруйте с помощью перманентного маркера 3 емкости для титрования (баночки для анализов с красной крышкой);
8) Извлеките пипетку Пастера на 5 мл из упаковки и подпишите на её верхней части «NaOH»;
9) С помощью пипетки Пастера на 5 мл перенесите в каждую емкость для титрования по 10 мл раствора NaOH 0,1 М;
10) Поставьте открытые емкости для титрования №2 и №3 с раствором NaOH на поверхность почвы в соответствующих емкостях на 0,5-1 л №2 и №3 (Рисунок 5);
|
|
|
Рисунок 5. Исследование почвенного дыхания |
11) Открытую емкость для титрования №1 с раствором NaOH поместите на дно пустой емкости на 0,5-1 л (емкость №1, контрольный эксперимент);
12) Закройте емкости крышкой и оставьте на сутки при комнатной температуре.
Титрование:
13) Извлеките вторую пипетку Пастера на 5 мл из упаковки и подпишите на её верхней части «HCl»;
14) Откройте капельницу, извлеките носик-дозатор и перенесите в неё с помощью пипетки Пастера 15 мл раствора соляной кислоты 0,1 M;
15) Вставьте носик-дозатор в капельницу;
16) Извлеките из емкости №1 емкость с раствором NaOH 0,1 М;
17) Добавьте в раствор 1 каплю раствора фенолфталеина;
Раствор NaOH должен приобрести малиновую окраску.
18) Разместите емкость для титрования на белой бумаге и, считая количество капель и перемешивая содержимое емкости вращательными движениями, добавляйте в емкость для титрования соляную кислоту из капельницы до полного обесцвечивания раствора;
В качестве дополнительного контроля можно взвесить капельницу с раствором соляной кислоты на весах перед экспериментом, а затем – после обесцвечивания раствора.
19) Зафиксируйте количество капель соляной кислоты, которое потребовалось для полного обесцвечивания раствора (Рисунок 6);
|
|
|
|
Рисунок 6. Окрашивание раствора до титрования (справа) и в момент завершения титрования |
|
20) Рассчитайте объем соляной кислоты, который потребовался для нейтрализации щелочи по формуле:
VHCl = Nкапель*Vкапли, где Nкапель – число капель, которое потребовалось для титрования, Vкапли – объем одной капли в мл;
Vкапли = 0,04 мл.
21) Вычислите количество моль щелочи, содержащееся в емкости для титрования по формуле:
n(NaOH) = CHCl*VHCl = 0,1*VHCl, где VHCl – объем соляной кислоты в миллилитрах, потраченный на титрование (рассчитан в п. 20);
22) Аналогично проведите титрование растворов NaOH 0,1 из емкостей №2 и №3 и рассчитайте количество моль щелочи, содержащееся в них;
23) Рассчитайте среднее количество моль щелочи в емкостях №2 и №3 по формуле: n(NaOH)ср = (n(NaOH)2 + n(NaOH)3)/2
24) Сравните количество моль щелочи в емкости №1 со средним количеством моль щелочи в емкостях №2 и №3;
Количество моль щелочи в емкостях №2 и №3 должно быть меньше, чем в емкости №1, поскольку часть щелочи прореагировала с CO2 по реакции: 2NaOH + CO2 = Na2CO3 + H2O
25) Вычислите массу CO2, выделившегося в результате дыхания почвы по формуле: m(CO2) = (n(NaOH)1 – n(NaOH)ср)*M(CO2) где n(NaOH)1 – количество NaOH, содержащееся в контрольной емкости №1, n(NaOH)ср – усредненное количество щелочи, содержащееся в емкостях №2 и 3, M(CO2) = 44 г/моль – молярная масса CO2.
26) Данные привести к мг СО2 на 100 гр влажной почвы. Когда вы получили по формуле объём СО2 в мг из навески почвы, которую брали для инкубирования, можно дальше пересчитать пропорцией, например, из 150 гр почвы выделилось 5 мг СО2.
Вы составляете пропорцию:
150 гр - 5 мг
100 гр - х
х=3,33
В базу данных вы вписываете значение: 3,33 мг/100 гр почвы.
Если у вас в школе есть щелочь, то вы можете провести дополнительные измерения (при желании, это не обязательно). Повторите эксперимент, подготовив новые емкости со щелочью и оставив их насыщаться:
- на 3 суток;
- на 7 суток.
Проведите титрование полученных растворов и вычислите выделяемые количества CO2 в процессе дыхания почвы.
Накопление органических веществ один из важнейших процессов при почвообразовании. Содержание органических веществ одна из важнейших характеристик плодородия почв.
В данном разделе представлена инструкция по определению количества органических веществ в почве. Для выполнения исследования вам потребуются следующие компоненты базового исследовательского набора:
- Перчатки;
- Стеклянные флаконы с крышкой;
- NaHCO3 (сода);
- Емкости для приготовления растворов соды;
- Стрипы;
- Пипетки Пастера на 5 мл.
И дополнительные компоненты:
- Дистиллированная вода (или бутилированная питьевая негазированная вода)
- Мерный стакан на 100 мл
Приготовление растворов соды:
1) Для приготовления 2% раствора соды необходимо взвесить 2 г соды, пересыпать навеску в емкость из набора и залить 100 мл воды, перемешать.
2) Для приготовления 5% раствора соды необходимо взвесить 5 г соды, пересыпать навеску в емкость из набора и залить 100 мл воды, перемешать.
3) Нагреть полученные растворы до 50 градусов (нагревать можно на водяной бане или вскипятить чайник, налить воду в емкость, подождать пока вода остынет до 90 градусов и поместить емкости с растворами в эту воду до нагревания)
Определение содержания органических веществ в почве:
1) В стеклянные флаконы с белыми крышками взвесить 1 г сухой почвы;
2) Навеску почвы залить 10 мл раствора горячей соды, закрыть крышку, взболтать;
3) Оставить флаконы с почвой и раствором соды на 24 часа при комнатной температуре: в первые 12 часов флаконы необходимо перемешать 3 раза, в последние 12 часов ничего делать не нужно;
4) Через 24 часа необходимо перелить небольшую часть полученного раствора из флакона перелить в крышку от этого флакона;
5) Сравнить растворы в крышечках флаконов со шкалой (Рисунок 7).

Рисунок 7. Шкала для оценки содержания углерода в почве, единицы измерения - количество мг углерода на кг почвы (мгС/кг почвы)*
*Шкала разработана Дрябловой Аленой МКУ ДО НСО НР СЮН, 8 класс
В данном разделе представлены инструкции по посеву и контролю процесса роста колоний азотфиксирующих бактерий. Для выполнения работ потребуются компоненты, которые представлены в наборе:
- Чашки Петри – емкость для посева колоний;
- Соли для приготовления среды Эшби – K2SO4, K2HPO4, NaCl, MgSO4*7H2O, CaCO3;
- Органические компоненты среды Эшби – агар и глюкоза;
- Пипетка Пастера
- Зубочистки – вспомогательный инструмент для распределения комочков земли;
Подготовительный этап:
Чашка Петри в наборе состоит из двух частей: чашки (глубокой, с меньшим диаметром) и крышки (часть с бОльшим диаметром).
1) Возьмите белый лист бумаги и обведите на нем контур чашки Петри (части с меньшим диаметром);
2) Нарисуйте в контуре чашки Петри трафарет (Рисунок 8);

Рисунок 8. Трафарет
Приготовление вспомогательного раствора:
Вспомогательный раствор солей готовят один раз и используют для создания сред в течение всего исследования.
1) В мерную колбу объемом 1 литр налейте 300-400 мл воды;
2) Высыпьте в колбу с водой всё содержимое флаконов с NaCl, K2SO4, MgSO4*7H2O и К2HPO4 и перемешайте смесь;
3) Доведите объем раствора до отметки 1 литр и проконтролируйте, что все соли полностью растворились (об этом свидетельствует отсутствие осадка на дне колбы);
Если в вашей лаборатории нет мерной колбы, то вы можете воспользоваться мерным стаканом (химическим или бытовым) для отбора нужного объема жидкости.
Для исследования роста колоний на одном образце почвы следует поставить 3 параллельных эксперимента в 3-х чашках Петри. На каждую чашку Петри потребуется 20 мл среды Эшби.
Приготовление среды Эшби (200 мл):
Если в вашей лаборатории нет аналитических весов, то для подготовки навесок вы можете использовать бытовые (кухонные) весы.
1) На весах подготовьте навески:
1а) 1 г CaCO3;
1б) 3 г Агара;
1в) 4 г глюкозы;
2) В химический стакан налейте 200 мл вспомогательного раствора;
3) В стакан с раствором перенесите навески CaCO3, Агара и глюкозы;
4) Смесь в стакане перемешать до состояния однородной взвеси;
5) Смесь вскипятить на плите или в микроволновой печи до максимального растворения компонентов (часть взвеси не растворится, однако большая часть компонентов должна перейти в раствор);
6) Смесь охладите до 50-600С и заполните ей чашки Петри[1] так, чтобы смесь полностью покрывала дно (должно уйти ~25 мл на одну чашку);
Если смесь успела охладиться и застыть в стакане, то вы можете повторно растопить её на плитке или в микроволновой печи.
Подготовка почвы для анализа:
1) Образцы почвы высушить, убрать крупные остатки растительности, камни, мусор;
Рекомендуем также просеять почву через сито с диаметром ячеек 1-2 мм.
2) Перенести ~3 грамма почвы пустую чашку Петри или любую другую емкость с бортиком;
3) К почве с помощью пипетки Пастера по каплям добавлять дистиллированную воду до получения пастообразной массы;
4) Увлажненную почву (полученную пасту) тщательно перемешать с помощью зубочистки (Рисунок 9).

Рисунок 9. Внешний вид увлажненной почвы (пастообразная масса)
Посев:
1) Из увлажненной почвы отделить 40-50 комочком диаметром ~3-4 мм;
2) Чашку Петри, заполненную застывшей средой, разместить на трафарете, совместив края чашки с контуром трафарета;
3) В чашке Петри в узлах трафарета разместите подготовленные комочки земли так, как показано на Рисунке 10;
Процесс размещения комочков земли в узлах трафарета удобно осуществлять с помощью зубочисток.

Рисунок 10. Схема расположения комочков земли в чашке Петри
4) Чашки Петри накрыть крышками и оставить на 3-4 дня при комнатной температуре.
Желательно хранить чашки Петри во влажной атмосфере. Для создания более влажной среды можно накрыть чашки «колпаками» из пластиковых бутылок.
Наблюдаемые эффекты:
1) Через 3-4 дня после посева вокруг комочков должны появиться обрастания (Рисунок 11);
Рисунок 11. 4-х суточные культуры
2) Через 6-8 дней обрастания должны приобрести окрашивание (Рисунок 12);
Наиболее распространенный и хорошо изученный Azotobacterchroococcum (обитает в почвах всех типов, кроме кислых) образует колонии с бурым, почти чёрным пигментом. Для Azotobacteragilis характерны бесцветные колонии. Azotobactervinelandii образует колонии с флуоресцирующую желтовато-зеленоватой окраской.

Рисунок 12. Внешний вид колоний на 7-8 день после посева
Описание результатов:
1) Сфотографируйте содержимое чашек Петри через 4, 7 и 10 дней после посева;
2) Зафиксируйте данные своих наблюдений в лабораторном журнале. Данные следует фиксировать в виде таблицы (Таблица 1).
Таблица 1. Описание развития колоний бактерий
|
№ образца |
|
||
|
Дата отбора |
|
||
|
Дата посева |
|
||
|
Число дней после посева |
4 |
Запишите общее количество обрастаний, их % обросших комочков, число потемневших колоний и их % от числа обрастаний для 4, 7 и 10 дня |
|
|
7 |
|
||
|
10 |
|
||
Данный этап работ рекомендуется проводить через 6-7 дней после посева культуры бактерий.
В данном разделе представлены инструкции по микроскопическому исследованию колоний азотфиксирующих бактерий Для выполнения работ потребуются компоненты, которые представлены в наборе:
- Предметные стекла – стекла для микроскопического исследования;
- Пипетка Пастера;
- Зубочистки – инструмент для отбора пробы;
- Фуксин Циля – краситель;
- Тушь – краситель;
Дополнительно рекомендуем приобрести в аптеке спиртовые салфетки для обеззараживания стекол.
Ход работы:
1) Протереть предметное стекло спиртовой салфеткой для удаления загрязнений и жирового слоя;
2) В чашках Петри, засеянных 6-7 дней назад, выберите несколько колоний («обрастаний») с разной окраской;
3) В лабораторном журнале схематично отобразите чашку Петри с трафаретом внутри (должен получиться рисунок аналогичный Рисунку 6);
4) Отберите пробу от заинтересовавших вас колоний для микроскопического исследования: с помощью зубочистки зачерпните небольшое количество биомассы и перенесите на стекло;
5) Затем возьмите чистое предметное стекло и его краем, одним четким движением, размажьте по центральной части предметного стекла биомассу с поверхности зубочистки. Посушите препарат пару минут на воздухе (или можно зафиксировать препарат проведя 2-3 раза над огнем спиртовки);
6) На схеме в лабораторном журнале (см. пункт 3 данного раздела) отобразите место, в котором вы взяли исследуемый образец. Образцу присвойте номер и зафиксируйте цвет колонии;
7) С помощью пипетки Пастера на предметное стекло в центр площади, покрытой образцом, нанесите каплю фуксина Циля, оставьте окрашиваться на 1 минуту;
При нанесении красителей (туши и фуксина Циля) важно наносить минимально возможный объем красителя – это предотвратит сильное растекание образца по стеклу.
8) На край стекла, с помощью пипетки Пастера, нанесите каплю туши;
9) Зубочисткой провести тонкую дорожку из капли с тушью до фуксина Циля, таким образом добавляя второй краситель. Перемешайте красители и биомассу, находящиеся на стекле, до равномерного тонкого слоя грязно-розового цвета;
10) Получившийся в пункте 9 препарат высушить на воздухе;
Процесс сушки может занимать от 10 до 30 минут.
11) На препарат нанесите каплю воды (такая подготовка препарата называется водной иммерсией) и изучите полученный препарат с помощью светового микроскопа при увеличении х100 (объектив 40, окуляр 10);
Если в используемом микроскопе доступно увеличение х1000, то при подготовке препарата следует использовать масляную иммерсию – после сушки (пункт 10) на препарат нанести каплю масла.
Слева на Рисунке 13 приведен снимок препарата при увеличении х400 (водная иммерсия), а правая часть Рисунка 17 отображает снимок препарата при увеличении х1000 (масляная иммерсия).
Если вашей проектной команде не удалось обнаружить на изучаемом препарате клеток Azotobacter (описание клеток приведено ниже), то эксперимент можно провести снова. Для этого нужно помыть предметные стекла проточной водой и повторить всю последовательность действий с той же самой колонией или выбрать для изучения другой образец).

Рисунок 13. Пример снимков препарата при х400 (слева) и х1000 (справа)
Информация об исследуемых объектах:
Клетки бактерий рода Azotobacter относительно крупные (1-2 мкм в диаметре) и, как правило, имеют овальную форму. Однако, встречаются представители Azotobacter с разнообразными формами клеток — от палочковидной до сферической. На микроскопических препаратах клетки могут располагаться одиночно, парами, неправильными скоплениями. В некоторых случаях можно встретить цепочками из клеток Azotobacter различной длины. Формируют особые покоящиеся формы — цисты (пузыря, защитной оболочки вокруг клеток).
Рекомендуется сделать снимки препаратов (для этого можно направить камеру смартфона в окуляр микроскопа). Фотографии можно распечатать и вклеить в свой лабораторный журнал.
В данном разделе представлены инструкции по микроскопическому исследованию колоний бактерий Azotobaсter.
Для выполнения работ потребуются компоненты из набора «Охотник за микробами»:
- Предметные стекла – стекла для микроскопического исследования;
- Перманентный маркер;
- Пипетка Пастера на 1 мл;
- Зубочистки – инструмент для отбора пробы;
- Судан черный – краситель;
- Пинцет – вспомогательный инструмент для фиксации образцов;
- Изопропанол – реагент для промывки образцов.
Также вам потребуется спиртовка или зажигалка.
Ход работы:
1) На предметном стекле перманентным маркером нарисуйте несколько кругов (количество кругов должно быть равно количеству колоний, которые вы собираетесь исследовать), круги пронумеруйте.
2) Переверните стекло и дальнейшую работу проводите на обратной стороне стекла (сторона, на которой нарисованы круги должна оказаться внешней);
3) C помощью пипетки Пастера на 1 мл поместите каплю воды (~20-30 мкл) в центр каждого круга;
Помните, что стекло должно быть перевернуто. Маркер не смывается водой, однако может смываться реагентами, используемыми на других стадиях.
4) Чистой зубочисткой коснитесь культуры азотобактера, чтобы зацепить небольшое количество биомассы;
Не следует стараться отобрать большое количество бактерий: при рассмотрении в микроскопе они будут наслаиваться друг на друга и мешать наблюдению. Отобранное вами количество культуры может быть практически не различимо взглядом, однако его будет достаточно для исследования.
5) Разболтайте колонию в воде, стараясь при этом, чтобы разные капли воды не перемешивались между собой;
Каждую колонию нужно переносить в отдельную каплю, используя при этом чистую зубочистку.
6) Капли подсушите на воздухе до полного исчезновения влаги;
7) Зафиксируйте препарат с помощью пламени. Для этого следует взять предметное стекло пинцетом и несколько раз провести внешней поверхностью стекла (обратной от нанесенного образца) по пламени зажигалки или спиртовки (Рисунок 14);
|
|
|
Рисунок 14. Фиксация образца
|
8) Дождитесь, пока стекло остынет и на каждую высохший образец бактерий (пятно) нанесите каплю красителя – судана черного;
Пятно должно быть полностью покрыто красителем.
9) Оставьте стекло на 15 минут при комнатной температуре;
Краситель может растекаться в процессе окрашивания (Рисунок 15).
|
|
|
Рисунок 15. Процесс окрашивания препарата
|
10) Если через 15 минут краситель не высох, слейте его избыток в сливной стакан или раковину;
11) Промойте пятна изопропанолом, направляя струю из капельницы на пятна;
Процедуру промывки следует проводить аккуратно, чтобы не смыть бактерии. Для промывки всего стекла будет достаточно ~2-3 мл изопропанола.
12) Проанализируйте интенсивность окраски пятен. Если после промывки стекла бактерии окрасились в голубой цвет (как образцы бактерий №2 и 3 на Рисунке 16), значит они способны активно накапливать полимеров в своих клетках.
|
|
|
Рисунок 16. Результат окрашивания |
13) Высушите стекло и рассмотрите бактерии через объектив микроскопа при максимальном увеличении.
|
|
|
|
Рисунок 17. Бактерии, способные накапливать полимеры при увеличении.
|
|
Тема 12. Итоговое занятие. 3 ч. Защита исследовательских работ.
4.МЕТОДИЧЕСКОЕ ОБЕСПЕЧЕНИЕ
Материально-техническое обеспечение
|
№ п/п |
Наименование основного оборудования |
Кол-во единиц |
|
I. Технические средства обучения |
||
|
1. |
Компьютер с монитором комплектующими |
1 |
|
2. |
Ноутбук |
1 |
|
3. |
Звуковые колонки |
1 |
|
4. |
ПКс проектором |
1 |
|
II. Мебель |
||
|
1. |
Комплект мебели(стул ученический 30шт.,стол Ученический двух-местный–15 шт.) |
1 |
|
2. |
Стул учительский |
1 |
|
3. |
Стол учительский |
1 |
|
4. |
Лабораторный стол |
2 |
|
5. |
Шкаф для приборов лабораторный |
1 |
|
6. |
Шкаф для коллекций и дидактических материалов |
1 |
|
III. Лабораторное оборудование |
||
|
1. |
Весы лабораторные |
1 |
|
2. |
ЦифровойUSB-микроскоп |
1 |
|
3. |
Микроскоп биологический(электронный) |
5 |
|
4. |
Прибор контроля параметров почвы (pH, влагомер, измеритель плодородия) |
1 |
|
5. |
Цифровая лаборатория «Rove-Mate» c датчиками по биологии |
1 |
|
7. |
Лабораторное оборудование Центра «Точка роста» |
|
5. Список литературы
Для учащихся
1. Алексеев В.А. 300 вопросов и ответов по экологии/ В. А. Алексеев. - Ярославль: Акад. развития, 2003. - 240 с.: ил.
2. Ашихмина Т.Я. Школьный экологический мониторинг: учебно-методическое пособие для учителей и учащихся / Т. Я. Ашихмина, Г. Я. Кантор, А. Н. Васильева; ред. Т. Я. Ашихмина. - Москва: АГАР: Рандеву-АМ, 2000. - 387 с.
3. Вишнякова С.М. Экология и охрана окружающей среды. Толковый термилогический словарь. - М: изд. «Всемирный следопыт» 1998.
4. Добровольский, Г. В. Функции почв в биосфере и экосистемах / Г. В. Добровольский, Е. Д. Никитин. – М.: Наука, 1990. – 270 с.
5. Добровольский, Г. В. Экология почв. Учение об экологических функциях почв: учебник / Г. В. Добровольский, Е. Д. Никитин. – М.: Изд-во Моск. ун-та; Наука, 2006. – 364 с.
6. Мансурова С. Е., Кокуева Г. Н. Школьный практикум. Следим за окружающей средой нашего города. 9-11 классы. – М.:Гуманитарный издательский дом ВЛАДОС, 2014.
7. Мотузова, Г. В. Экологический мониторинг почв: учебник / Г. В Мотузова, О. С. Безуглова. – М.: Академический Проект; Гаудеамус, 2007. – 237 с.
Для педагога и родителей
1. Адам А.М. Глоссарий по экологии, экологической безопасности техносферы, природопользованию и охрана окружающей среды. - Томск: изд. «ТГАСУ» 2008 Алексеев С.В., Беккер Н.В. Изучаем экологию – экспериментально. Практикум по экологической оценке состояния окружающей среды. - С-Пб.: Респекс, 1993.
2. Александровский, А. Л. Эволюция почв и географическая среда / А. Л. Александровский, Е. И. Александровская; Ин-т географии РАН. – М.: Наука, 2005. – 223 с.
3. Алексеев С. В., Груздева Н. В., Тарасов С. В. Дидактические игры по экологии СПб.: СПГУПМ, 1992.- 90 с.
4. Григорьев Д.В. Внеурочная деятельность школьников. Методический конструктор: пособие для учителя / Д.В.Григорьев, П.В.Степанов. – М.: Просвещение, 2011. - 223с.- (Стандарты второго поколения).
5. ДереклееваН.И. Научно-исследовательская работа в школе. Текст. /Н.И. Дереклеева. М.: Вербум-М, 2001. - 46 с.
6. Добровольский, Г. В. Сохранение почв как незаменимого компонента биосферы: Функционально-экологический подход. – М.: Наука; МАИК «Наука/Интерпериодика», 2000. – 185 с.
7. Добровольский, Г. В. Функции почв в биосфере и экосистемах / Г. В. Добровольский, Е. Д. Никитин. – М.: Наука, 1990. – 270 с.
8. Добровольский, Г. В. Экологические функции почвы / Г. В. Добровольский, Е. Д. Никитин. – М.: Изд-во МГУ, 1986. – 137 с.
9. Заварзин, Г. А. Бактерии и состав атмосферы / Г. А. Заварзин. – М.: Наука, 1984. – 192 с.
10. Звягинцев, Д. Г. Биология почв / Д. Г. Звягинцев, И. П. Бабьева, Г. М. Зенова. – М.: Изд-во МГУ, 2005. - 445 с.
11. Карпачевский, Л. О. Экологическое почвоведение / Л. О. Карпачевский. – М.: ГЕОС, 2005. – 336 с.
12. Мотузова, Г. В. Экологический мониторинг почв: учебник / Г. В Мотузова, О. С. Безуглова. – М.: Академический Проект; Гаудеамус, 2007. – 237 с.
13. Научно-исследовательская работа учащихся: проблемы, условия и формы организации. /Сост. Шевченко А.П. - Самара: 1998.
14. Норенко И.Г. Экологическое воспитание в школе. Классные часы, игры, мероприятия. Волгоград: - изд. «Учитель», 2007. - 139 с.
15. Обухов А. С. В кн.: Развитие исследовательской деятельности учащихся: методический сборник. М.: Народное образование, 2001. С. 48-63.
16. Почвенно-экологический мониторинг и охрана почв / под ред. Д. С. Орлова, В. Д. Васильевской. – М.: Изд-во МГУ, 1994. – 272 с.
17. Практикум по экологии и охране окружающей среды. /А.И. Федорова, А.Н. Никольская. – М.: Владос, 2001.- 280 с.
18. Романова, Е.П. Методика оформления результатов исследования. / Е.П. Романова. – Тольятти: ИЭВБ РАН, 2001. - 37 с.
19. 19.Методичка «Всероссийский атлас почвенных микроорганизмов». Методические рекомендации.
Скачано с www.znanio.ru
[1] Средой стоит заполнять часть чашки Петри с меньшим диаметром
Материалы на данной страницы взяты из открытых источников либо размещены пользователем в соответствии с договором-офертой сайта. Вы можете сообщить о нарушении.